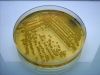
Imagen_0511.JPG

Curso 2007-08 |
 |
| العنوان |
+ |
- |
| اسم الملف |
+ |
- |
| التاريخ |
+ |
- |
| الموقع |
+ |
- |
|
|

Microscopio óptico46 مشاهده
|
|

Identificación bacteriana por probas bioquímicas60 مشاهدهManitol - Movilidade
|
|

Identificación bacteriana por probas bioquímicas53 مشاهدهKliger / TSI
|
|
Estriado sobre agar58 مشاهده
|
|

Antibiótico51 مشاهده
|
|

Laminocultivos90 مشاهده
|
|

Penicillium62 مشاهده
|
|

Preparación de medios en slant55 مشاهده
|
|

Medios de cultivo48 مشاهده
|
|

Escada McFarland52 مشاهده
|
|

Tratamento de residuos52 مشاهده
|
|

Enterotube67 مشاهده
|
|
|
|
